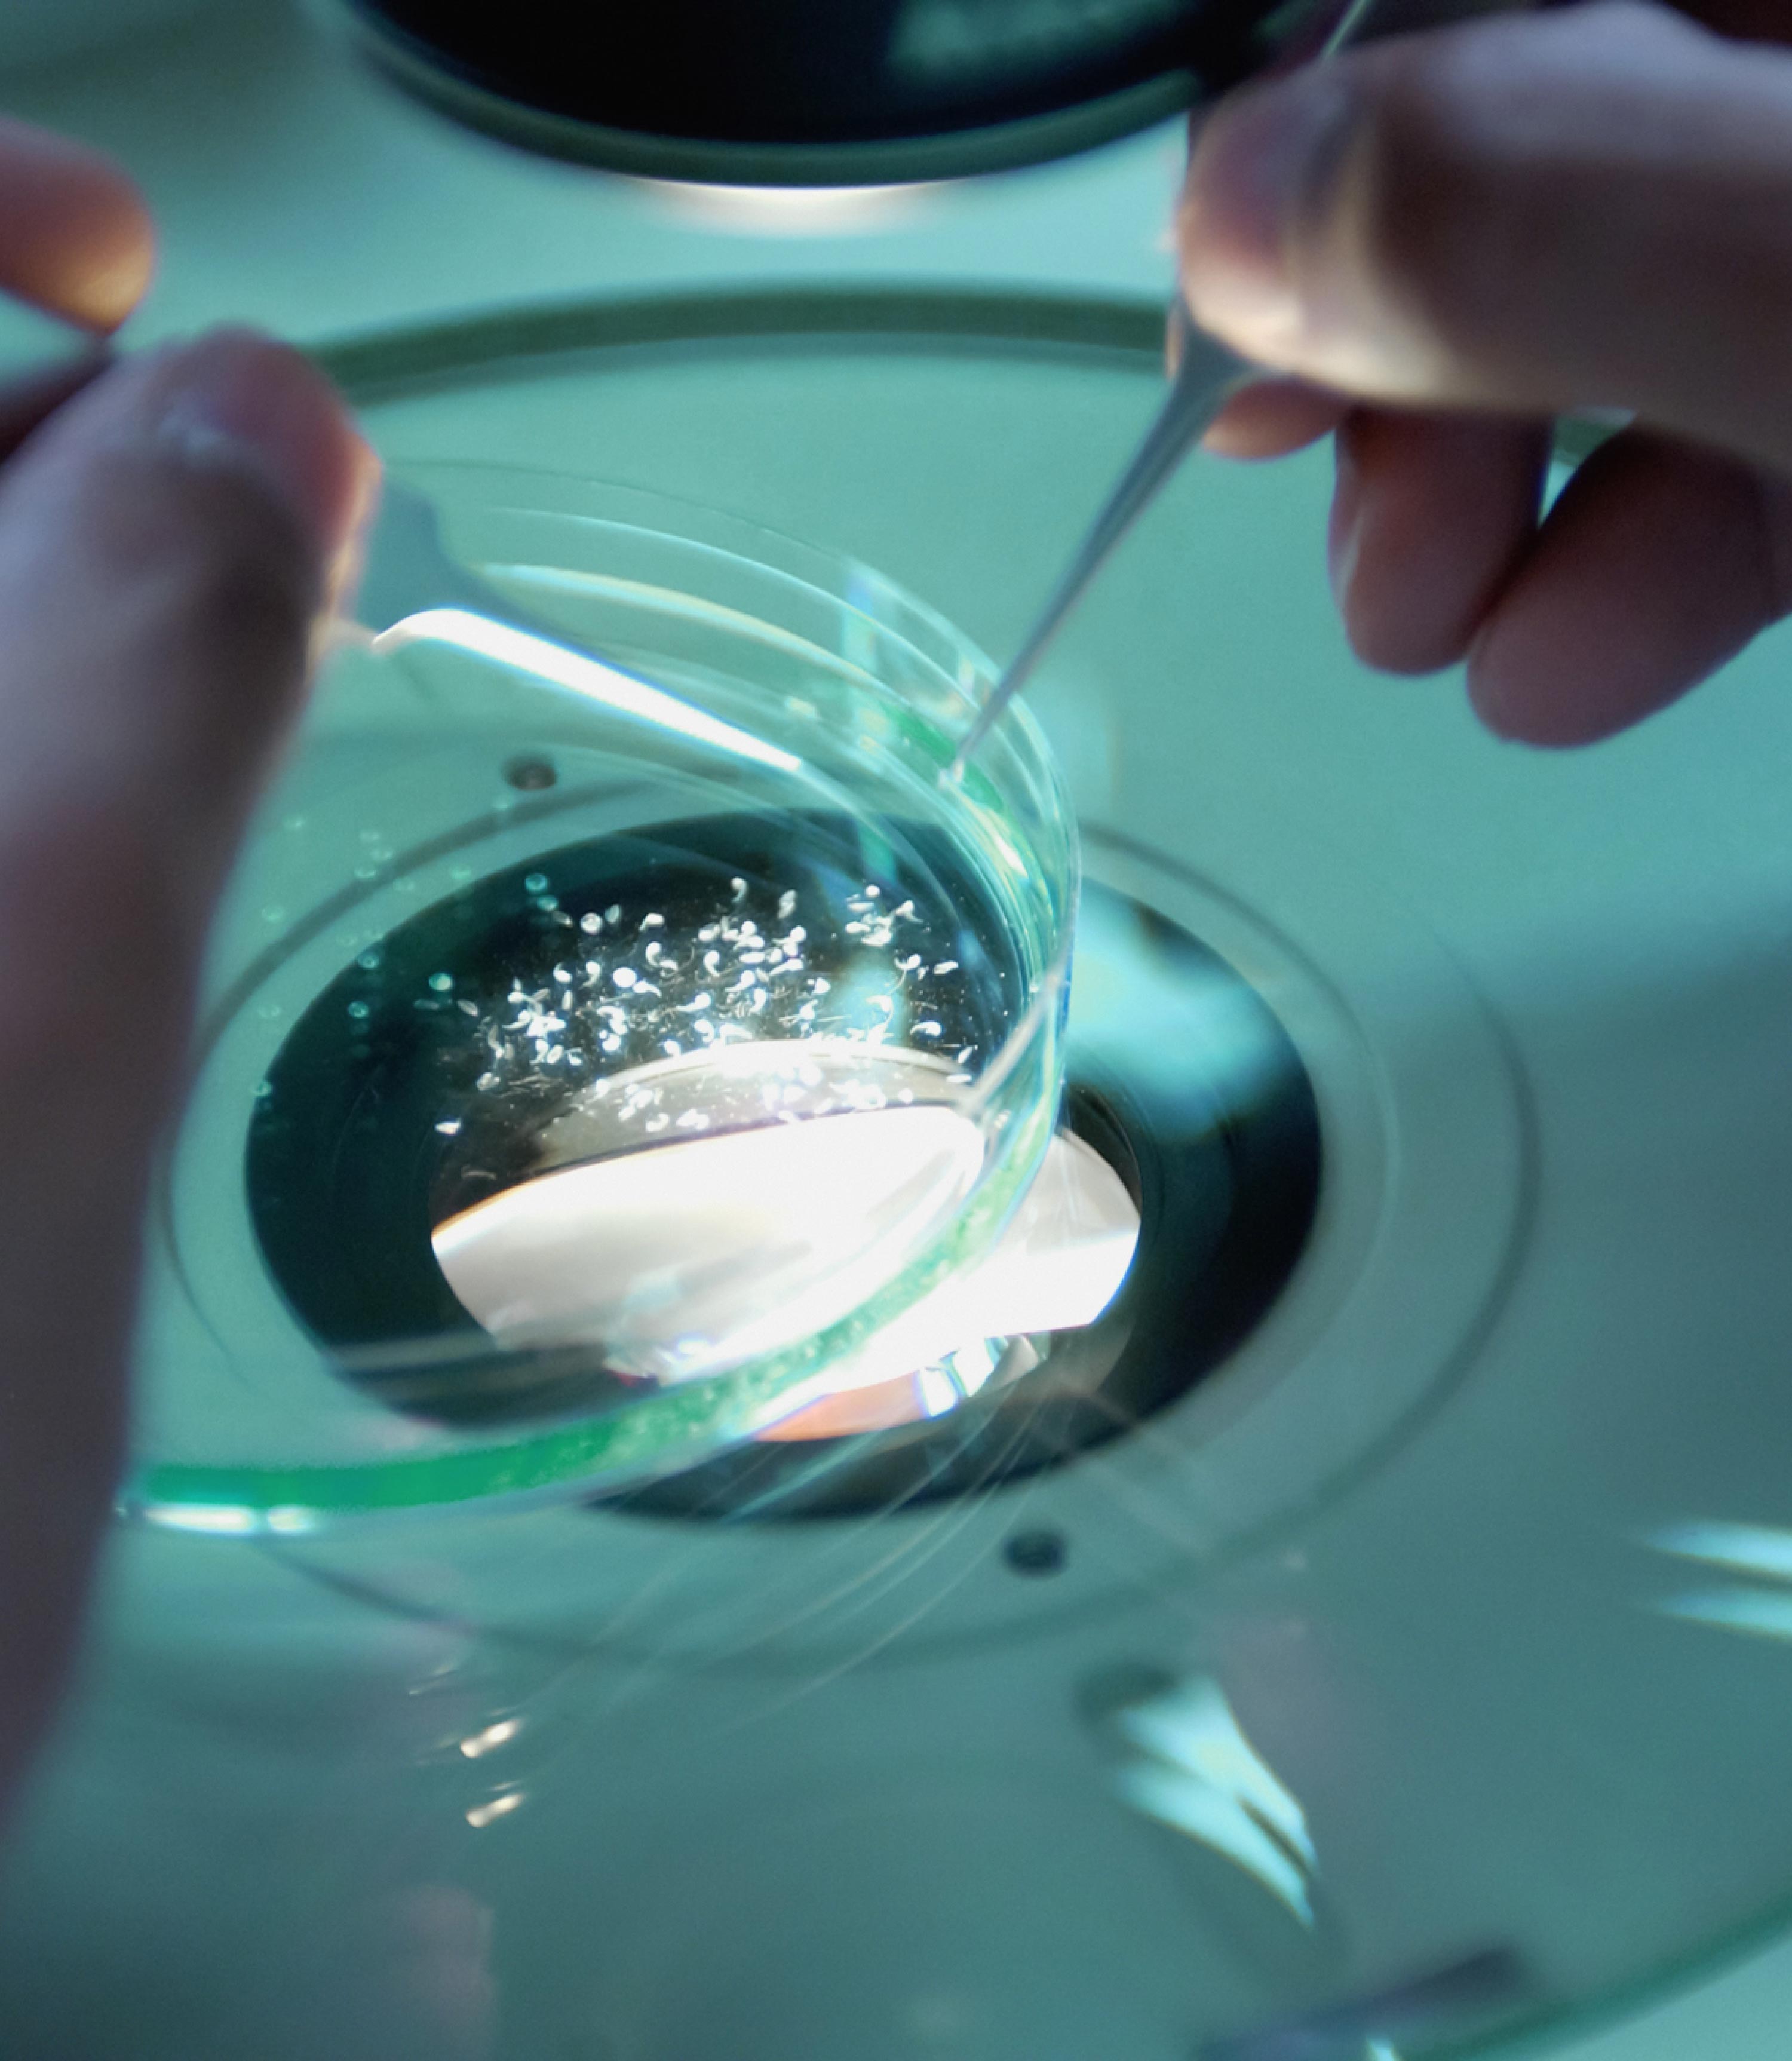

SVENSON 史云逊
Svenson is a medical-grade hair health management expert, offering a product-first medical systematic service and efficacious hair care products. For 60 years, Svenson has been bringing trichology to clients around the globe. Svenson’s journey began in 1956 with the opening of its first Hair Center in London. As Svenson’s tools and techniques have advanced across Hair Centers in Asia, Svenson’s core values have remained steadfast: committed and holistic hair and scalp care. Delivered by Svenson’s Trichologists and Hair Care Consultants who genuinely care about your well-being, and offers effective and scientific hair loss management.
We collaborated closely with the founder-led team to reimagine the brand’s appearance and behavior. Using Svenson’s exclusive medical services as the foundation, we developed a ‘medical prescription’ visual system. By highlighting a light medical attribute, we created a highly recognizable ‘S’ symbol and an innovative aesthetic for hair care technology.
Design with JAN Creation
SVENSON 史云逊
Svenson is a medical-grade hair health management expert, offering a product-first medical systematic service and efficacious hair care products. For 60 years, Svenson has been bringing trichology to clients around the globe. Svenson’s journey began in 1956 with the opening of its first Hair Center in London. As Svenson’s tools and techniques have advanced across Hair Centers in Asia, Svenson’s core values have remained steadfast: committed and holistic hair and scalp care. Delivered by Svenson’s Trichologists and Hair Care Consultants who genuinely care about your well-being, and offers effective and scientific hair loss management.
We collaborated closely with the founder-led team to reimagine the brand’s appearance and behavior. Using Svenson’s exclusive medical services as the foundation, we developed a ‘medical prescription’ visual system. By highlighting a light medical attribute, we created a highly recognizable ‘S’ symbol and an innovative aesthetic for hair care technology.
Design with JAN Creation